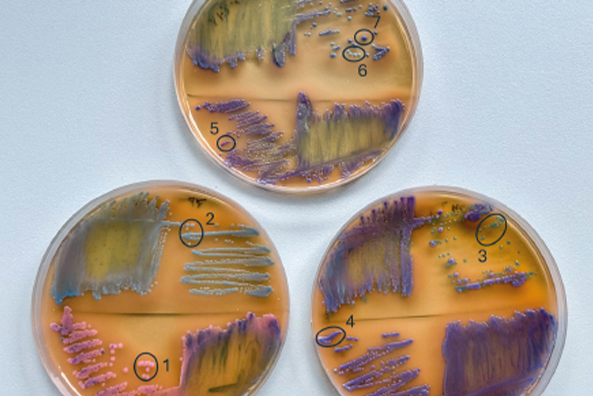

2025, sektorearekin lotura estutuz eta ikerkuntzari bultzada emanez
2025a urte esanguratsua izan da Leartiker-Esneki Zentroarentzat. Tokiko eta nazioarteko esnekigintzaren erronkak eta aukerak gertutik jarraituta, gure eginkizun nagusia sendo mantendu dugu: sektorearen beharrei erantzuna ematen dion ikerkuntza burutzea, esnekigintzan garapena eta berrikuntza sustatzea eta ezagutza espezializatuaren transferentzia burutzea. Urtean zehar garatutako proiektu, lankidetza, ekitaldi eta transferentzia saio guztiek sendotu dute gure lana, eta aldi berean, esnearen balio-katearen etorkizuna indartzeko tresna berriak ekarri dituzte.
2025a mugarri garrantzitsua izan da Leartiker-Esneki Zentroarentzat, bai garatutako proiektuen bilakaeragatik, bai lortutako erronka berriengatik, baita sektorearekin izandako harreman estu eta emankorragatik ere. Urte osoan zehar, gure jardueraren ardatz nagusia esnekigintzaren balio-katea indartzea izan da, sektoreari arreta zientifiko-teknikoa eta ezagutza espezializatua eskainiz.
Sektorearen beharrei erantzuteko martxan jarritako ikerketa-proiektuak, produktuen berrikuntzarekin lotutako jarduerak, ezagutzaren transferentzia praktikoa, azoketan eta jardunaldi espezializatuetan izandako parte-hartzea eta komunikazio-lan etengabea izan dira urteko ibilbidearen zutabe nagusiak.
Ikerkuntza, Garapen eta Berrikuntza proiektuak
Ikerketa esparruan, 2025ak aurrerapauso nabarmenak ekarri ditu gure jardueran. BEHITEK (Eusko Jaurlaritza) barne proiektua eta Neikerrekin eta 4 esne-ekoizlerekin elkarlanean izan dugun MILKSUIT (Lankidetza dirulaguntzak 2024, Eusko Jaurlaritza eta FEADER Europako Nekazaritza Garapenerako Funtsak kofinantzatuta) proiektuen garapenak, adibidez, behi-esne ustiategietan aplikatzen diren praktikak sakon aztertzeko eta horiek esnearen kalitatean zein gaztagintzarako duen egokitasunean duten eragin zuzena balioesteko aukera eman digu. Proiektu hauen bidez behi esnearen konposizioa eta bere ezaugarri teknologikoak baldintzatzen dituzten faktore nagusiak zehaztu, eta ustiategiko kudeaketaren alderdi ezberdinek (maneiuak, elikadurak, etab.) esnearen kalitate teknologikoan nola eragiten duten ikertu dugu. Horri esker, behi-gazta onduaren ekoizpenerako ezinbestekoak diren prozesu-egokitzapenak aplikatu ditugu kalitate goreneko gaztak lortu asmoz.

Esneki Zentroaren nazioarteko jardunean ere 2025a urte erabakigarria izan da, eta sektoreko eragile gisa duen eginkizuna indartu du, Europako bi proiektu estrategiko gidatuz eta koordinatuz: KNOW N CHEESE (Interreg POCTEFA) eta DAIRITAL (Interreg SUDOE). KNOW N CHEESE-en, partzuergoaren koordinazio globala zuzentzeaz gain, Esneki Zentroak ikerketa-jarduera handia egin du arlo kritikoetan: elikagaien segurtasuna, sortzen ari diren arriskuak (STEC, toxinak, hartzidura-akatsak) eta klima-aldaketak esnearen propietate teknologikoetan duen eragina. Lan horiei esker, POCTEFA lurraldean esneki berrien garapen pilotuarekin batera, gainerako partzuergoarekin elkarlanean, ekoizleentzako eta ikertzaileentzako prestakuntza-esparru berritzaile bat egituratu ahal izan da, bai eta kontsumitzaileak sentsibilizatzeko esparru bat ere. Esneki Zentroak esparru hori HAZI Fundazioarekin batera gidatu du, eta 2026an sendotu egingo da, zientzian, tradizioan eta berrikuntzan oinarritutako trebakuntzan erreferentzia gisa.
DAIRITAL proiektuan, Esneki Zentroak proiektuaren lidergo orokorra hartzen du bere gain, eta komunikazioaren koordinazioan funtsezko eginkizuna partekatzen du HAZI Fundazioarekin. Horri esker, bermatzen dira koherentzia teknikoa, proiektuaren ikusgarritasun egokia eta sortutako ezagutzaren transferentzia eraginkorra abeltzaintzara, gaztandegietara, sektoreko eragileetara eta proiektuko bazkideengana. Maila teknikoan, Esneki Zentroak funtsezko zereginak betetzen ditu: eraldaketa ekologikoek eta digitalek esnearen propietateetan duten inpaktua ebaluatzen du; jezte robotizatuak eragindako alterazioak aztertzen ditu; MIR teknologiak baliozkotzen ditu; eta tresna digital berrien garapenean laguntzen du, gaztetan akatsak identifikatzeko etorkizuneko aplikazioa barne, gaur egun definizio eta lizitazio fasean dagoena. Lan-esparru horiei guztiei esker, Esneki Zentroa erreferente zientifiko eta koordinatzaile estrategiko bihurtzen da Europako hego-mendebaldean, esne-sektorearen modernizazioa, digitalizazioa eta iraunkortasuna bultzatzeko.
Elikagaien segurtasunaren arloan ere ikerketa-proiektu berriak jarri ditugu martxan, SHIGA (Eusko Jaurlaritza) eta CRISPR proiektuak, besteak beste. SHIGA proiektuaren helburua da Escherichia coli Shiga toxina ekoizlea (STEC) esnean eta esnekietan detektatzeko metodo azkarrago, errazago eta errentagarriago bat garatzea. Patogeno honek garrantzi berezia du osasun publikoan, bereziki esne gordinarekin egindako gaztekin izan dezakeen loturagatik.
Bestalde, CRISPR proiektuaren bidez, CRISPR-Cas9 teknologia aplikatzen ari gara gene espezifikoak dituzten bakterioak inaktibatzeko, elikagai-matrize konplexuetan. Antibiotikoekiko erresistentziak eta komunitate mikrobiarren kudeaketa zehatzaren beharrak kontuan hartuta, teknologia honek bakterio-komunitateak modu selektiboan eraldatzeko aukera berritzailea eskaintzen du.
Bi proiektuen emaitzek ezagutza zientifikoa sendotzea ez ezik, etorkizunean ikerketa-tresna berrien eta aplikazio bioteknologiko praktikoen oinarria ezartzea dute helburu, Euskal Herriko esne-sektorearen segurtasuna eta lehiakortasuna indartuz.
Bestetik, hainbat dira eskuartean izan ditugun garapen eta berrikuntza proiektuak. Horien artean, aipatzekoa da Chileko La Oveja Vasca gaztandegiarekin egindako lankidetza. Aurten ere bertara joateko aukera izan dugu, gure aholkularitza teknikoari esker bertan ekoitzitako gazten dibertsifikazioan eta balio-erantsian sakontzen laguntzeko. Zorionekoa da, gainera, azken urtean lortutako aurrera-pausuen emaitza: Chileko Encuentro Quesos nazioarteko txapelketan lau domina eskuratu dituzte elkarlanean garatutako gaztek. Lorpen honek egiten ari garen lanaren eraginkortasuna berresten du.
Nabarmentzekoa da Moraita gaztandegiarekin elkarlanean garatutako Auntzai Urdina gazta, HAZI Fundazioak Gaztaberri gazta-sortan barneratutako gazta berria. Halaber, Giberri Gazta gaztandegi berriarekin egindako lehen lankidetzak emaitza bikainak utzi ditu, ahuntz-gazta sorta berria garatuz eta gaztandegi gazte honen posizionamendua sendotzen lagunduz. Xarrondo esnetegiarekin egindako lanean, berriz, esneki hartzitu berriak garatu ditugu, tokiko lehengaien erabilera eta prozesu naturaletan oinarritutako produktu-lerro espezifikoa sortuz. Horiez gain, hainbat berrikuntza garapen burutu ditugu beste gaztandegi batzuetan ere: Ekia (Nafarroa), Lleldiria (Kantabria), O Rexo (Galizia), eta Caprarius (Fuerteventura).
Lankidetza guzti hauen helburu komuna izan da produktuen dibertsifikazioa, kalitatearen hobekuntza eta merkatuan posizionamendu sendoagoa lortzea. Proiektu hauek agerian uzten dute Esneki Zentroak sektorean duen eginkizun estrategikoa: ekoizleei balio erantsia ematea, berrikuntza teknikoa sustatzea eta merkaturatze arrakastatsurako tresna eraginkorrak eskaintzea.
Aholkularitza teknologikoa eta ezagutzaren transferentzia
Azken urtean Euskal Herriko zein estatu mailako beste hainbat gaztandegirekin egin dugu lan, berrikuntza sustatu eta aholkularitza teknikoa eskainiz. Ekoizpen-eredu eta errealitate oso ezberdinetara egokituz, gure ezagutza modu eraginkorrean transferitu dugu, gaztandegi bakoitzaren behar bereziei erantzun pertsonalizatua emateko. Horri esker, produktu berrien garapenean eta dibertsifikazioan, ekoizpen-prozesuen optimizazioan, produktuaren kalitatearen hobekuntzan, autokontrol-planen garapenean eta, oro har, sektorearen lehiakortasuna sendotzen lagundu dugu.
Horrez gain, azken urtean eskaini ditugun formazio saio espezializatuetan ia 100 profesionalek hartu dute parte. Prestakuntza hauek gazta eta esneki ezberdinen teknologiarekin lotutako ikastaroak izan dira, bai eta afinazioaren inguruko saio espezializatuak ere, MONS Formation-ekin dugun lankidetza-hitzarmenari esker. Aipatzekoa da, halaber, aurten berriz ere David Asher gurean izateko aukera izan dugula, gaztagintza naturalaren ikuspegia eta artisau-teknikak partekatu dituen formazio saioarekin.
Gaztagintza-errealitate ezberdinak ezagutzen
Urtean zehar hainbat herrialde eta eskualdetako gaztandegiak bisitatzeko aukera izan dugu, sektorearen errealitate anitzak zuzenean ezagutuz. Gertu ditugun Kantabria eta Galiziako gaztandegiez gain, gure jarduna Kanariar Uharteetara, Europa Erdialdera eta Hego Amerikara ere zabaldu dugu, ikuspegi profesionala eta nazioarteko harremanak indartuz.
Urtearen hasieran Boliviako 7 Familias Dairy gaztandegitik gonbidapena jaso genuen, herrialdeko esneki-sektorearen beharrak eta erronkak sakon ezagutzeko. Bisita horren bidez, Boliviako ekoizleen egunerokoa eta garapen-aukera nagusiak aztertu genituen, eta sektorearen lehiakortasuna hobetzeko elkarlan-ildo berriak aztertu genituen.
Bestalde, Kanariar Uharteetan izan ginen QueRed elkartearen urteko bilkuraren baitan, estatu mailako gaztandegiak biltzen dituen sarearekin batera. Topaketa horrek sektoreko joera berriak partekatzeko, esperientzien arteko trukea sustatzeko eta gaztagintzaren etorkizuneko erronka komunak lantzeko espazio aberasgarria eskaini zigun.

Horiez gain, FACENetwork (Farmhouse and Artisan Cheese & Dairy Producers European Network) elkartearen bilkuraren testuinguruan, Eslovenia eta Kroaziako artisau-gaztandegiak bisitatzeko aukera izan genuen. Esperientzia horrek Europako Erdialdeko gaztagintza-eredu jasangarriak, tradizioa eta berrikuntza uztartzen dituzten praktikak eta tokiko nortasun gastronomiko sendoa mantentzeko egiten duten ahalegina gertutik ezagutzeko aukera eman zigun. Bisita tekniko horiek gure ikuspegia aberastu dute, eta nazioarteko sareekin dugun harremana sendotzeko aukera paregabea izan da, etorkizunean lankidetza estrategiko berriak irekitzeko oinarriak finkatuz. Azkenik, Rovinj-en (Kroazia) izandako bilkura ez zen soilik topagune profesional emankorra izan: erronka berriarekin itzuli ginen etxera! Izan ere, Esneki Zentroa izango da 2026ko FACENetwork bilkuraren antolatzailea. Hori gure lanaren aitortza garrantzitsua da, nazioarteko sareak guregan jarritako konfiantzaren adierazle, eta aldi berean aukera estrategikoa Euskal Herriko gaztagintza- eta esnekigintza-sektorea Europa mailan ikusgarriago bihurtzeko.
Era berean, MilkSuit proiektuaren baitan Suitzako Alpeetako hainbat gaztandegi bisitatu ditugu, behi-gazta kalitate handiko ekoizpenean munduko erreferentetzat hartzen den eskualdean. Bidaia hau proiektuaren mugarrietako bat izan da, eta bertan jasotako ezagutzak gure lan-ikuspegia nabarmen aberastu du, bai ekoizleen eguneroko kudeaketari dagozkion praktika eraginkorretan, bai esnearen kalitate teknologikoa hobetzeko estrategia aurreratuetan aplikatzeko moduko ideia berriak ekarriz.
Azoka eta gazta txapelketan parte-hartzea
Urtean zehar hainbat azokatan eta gazta-txapelketetan parte hartu dugu esnekigintzaren eta gaztagintzaren kultura zabaltzeko. Besteak beste, Espainiako Gazta Onenen GourmetQuesos Txapelketan 15. edizioan izan gara, non Esneki Zentroak 2015etik epai-mahaikide gisa jarduten duen. Halaber, Lanzaroten ospatutako Agrocanarias txapelketan, Tours-en ospatu den Mondial du fromage gazta txapelketan, zein Chileko Encuentro Quesos txapelketan ere epaimahai lanak egiten jardun gara.

Aipatzekoa da, era berean, Igorren izandako II. Esneki eta Gazta Azokan antolatu dugun gazta-dastaketa, publikoak sektoreko aniztasuna gertutik ezagutzeko aukera eskaini zuena esneki produktuak balioan jarriz.
Esneki Zentroa, gainera, aurten laugarren aldiz ospatu den ESNEKI azokaren eta Euskal Herriko Gazta eta Esneki Txapelketaren antolatzaileetako bat da. Bi ekitaldi hauek urteko hitzordu estrategikoen artean kokatzen dira, esnekigintzaren eta gaztagintzaren balioa eta aniztasuna zabaltzeko gune nagusi bihurtu direlako.
Aipatzekoa da sektoreko hainbat erakunderekin mantendu dugun lan-harreman estua eta etengabeko lankidetza. Euskal administrazioarekin dugun presentzia ere aktiboa da: Eusko Jaurlaritzako foro espezializatuetan parte hartzen dugu, besteak beste Segurtasun Mahaian, “Elikadura eta Osasuna” foro espezifikoan eta RIS3 espezializazio adimendunaren baitako talde eragileetan. Era berean, HAZI Fundazioarekin eta ELIKA Fundazioarekin ditugun aliantzek gure jarduera sendotzen dute eta sare-lanean oinarritutako ikuspegi integrala ahalbidetzen dute.
Esneki Zentroa, halaber, sektoreko elkarte nagusietako kide aktiboa da: QueRed (Red Española de Queserías de Campo y Artesanas), estatu mailako gaztandegi artisauen sare zabala, FACEnetwork (Farmhouse and Artisan Cheese and Dairy Producers European Network), Europa osoko artisau esnekigileen komunitate estrategikoa eta Euskal Esnekigileen Elkartea, 2023an sortua, eta zeinaren dinamizazio eta kudeaketa operatiboa gure gain dagoen.
Harreman eta parte-hartze sare zabal honek aukera ematen digu sektoreko joerak gertutik jarraitzeko, ezagutza trukatzeko eta gure jardunaren bidez gaztagintza eta esnekigintza artisauaren garapenean eragin zuzen, esanguratsu eta positiboa izateko.
Azken batean, 2025a urte oparoa eta emankorra izan da Esneki Zentroarentzat. Egindako lanaren balantzeak argi erakusten du gure jarduera sektoreak behar duen erreferentzia zientifiko eta teknologikoa bihurtzen ari dela, eta bide horretan sakontzeko konpromisoa are sendoagoa dela.
2026ari begira, erronka berriak ditugu mahai gainean, baina baita lankidetza-sare sendo eta motibatu bat ere. Horrek guztiak indarra eta konfiantza ematen digu esnekigintzaren etorkizuna eraikitzen jarraitzeko.
Aurten, ilusio eta determinazio bereziz helduko diegu aukera eta proiektu berriei. Eta, zalantzarik gabe, 2026ko FACEnetwork bilkura Euskal Herrian antolatzea izango da urteko erronka nagusietako bat: sektorearentzat aukera estrategikoa, gure ezagutza, eredua eta komunitatea nazioarteko eszenara eramateko aukera bikaina.
Ekin diezaiogun!